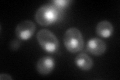
YHR027C
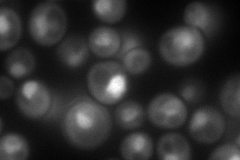
YHR027C
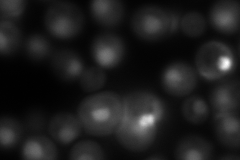
YHR027C
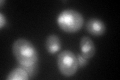
YHR027C
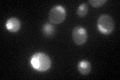
YHR027C

View description
Non-ATPase base subunit of the 19S regulatory particle of the 26S proteasome; may participate in the recognition of several ligands of the proteasome; contains a leucine-rich repeat (LRR) domain, a site for protein-protein interactions
Localization:
Intensity:
Fold change:
Significance:
-
C’ GFP library in SD
nucleus:cytosol109.24 -
N' NOP1pr-GFP in SD
nucleus148.587 -
N' TEF2pr-mCherry in SD
nucleus222.54 -
N' NATIVEpr-GFP in SD

nucleus110.108 -
N' TEF2pr-VC and Cyto-VN in SD

nucleus52.3465 -
C’ GFP library in SD+DTT
nucleus.cytosol101.110.92No -
C’ GFP library in SD+H2O2

nucleus.cytosol127.051.16No -
C’ GFP library in Starvation Media
nucleus,cytosol111.21.01No -
C’ GFP library on the background of Pup2-DaMP

nucleus:cytosol -
C’ GFP library on the background of CCT mutant

nucleus:cytosol78.10410.714906No
